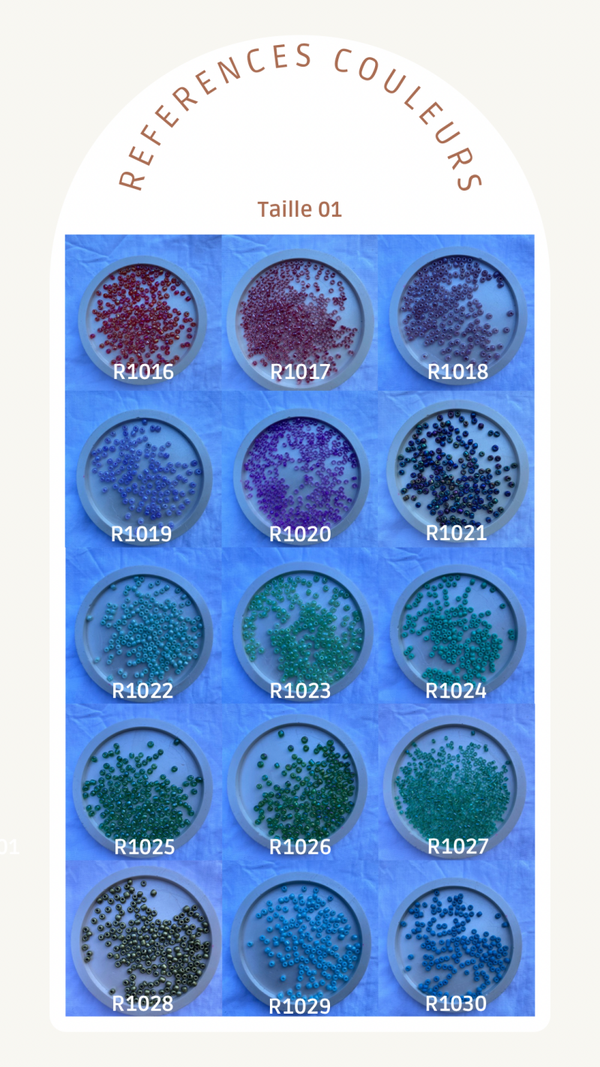
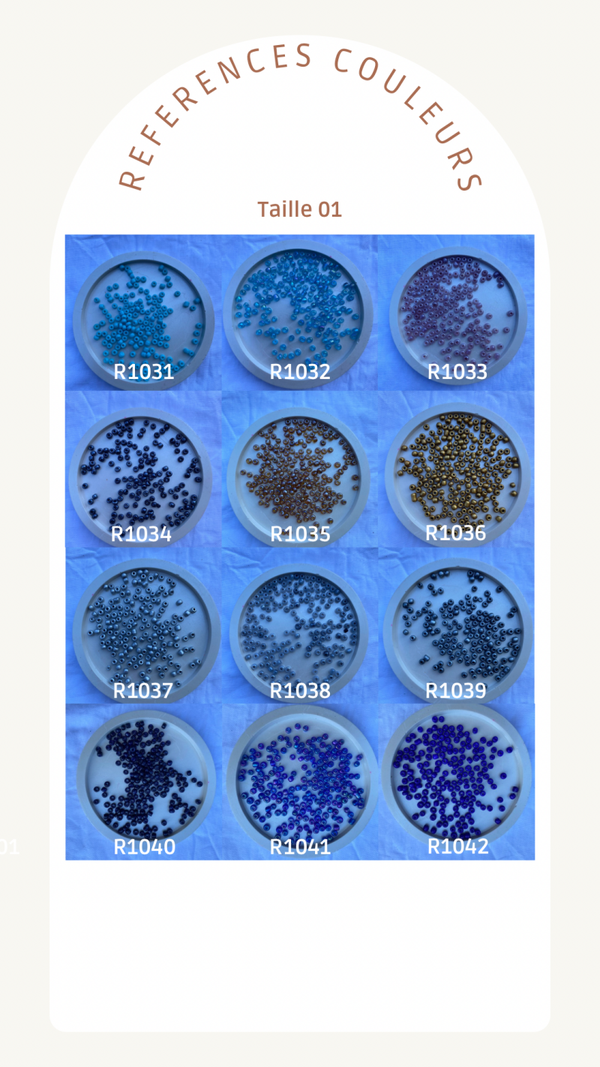

20cm / R1001
20cm / R1002
20cm / R1003
20cm / R1004
20cm / R1005
20cm / R1006
20cm / R1007
20cm / R1008
20cm / R1009
20cm / R1010
20cm / R1011
20cm / R1012
20cm / R1013
20cm / R1014
20cm / R1015
20cm / R1016
20cm / R1017
20cm / R1018
20cm / R1019
20cm / R1020
20cm / R1021
20cm / R1022
20cm / R1023
20cm / R1024
20cm / R1025
20cm / R1026
20cm / R1027
20cm / R1028
20cm / R1029
20cm / R1030
20cm / R1031
20cm / R1032
20cm / R1033
20cm / R1034
20cm / R1035
20cm / R1036
20cm / R1037
20cm / R1038
20cm / R1039
20cm / R1040
20cm / R1041
20cm / R1042
21cm / R1001
21cm / R1002
21cm / R1003
21cm / R1004
21cm / R1005
21cm / R1006
21cm / R1007
21cm / R1008
21cm / R1009
21cm / R1010
21cm / R1011
21cm / R1012
21cm / R1013
21cm / R1014
21cm / R1015
21cm / R1016
21cm / R1017
21cm / R1018
21cm / R1019
21cm / R1020
21cm / R1021
21cm / R1022
21cm / R1023
21cm / R1024
21cm / R1025
21cm / R1026
21cm / R1027
21cm / R1028
21cm / R1029
21cm / R1030
21cm / R1031
21cm / R1032
21cm / R1033
21cm / R1034
21cm / R1035
21cm / R1036
21cm / R1037
21cm / R1038
21cm / R1039
21cm / R1040
21cm / R1041
21cm / R1042
22cm / R1001
22cm / R1002
22cm / R1003
22cm / R1004
22cm / R1005
22cm / R1006
22cm / R1007
22cm / R1008
22cm / R1009
22cm / R1010
22cm / R1011
22cm / R1012
22cm / R1013
22cm / R1014
22cm / R1015
22cm / R1016
22cm / R1017
22cm / R1018
22cm / R1019
22cm / R1020
22cm / R1021
22cm / R1022
22cm / R1023
22cm / R1024
22cm / R1025
22cm / R1026
22cm / R1027
22cm / R1028
22cm / R1029
22cm / R1030
22cm / R1031
22cm / R1032
22cm / R1033
22cm / R1034
22cm / R1035
22cm / R1036
22cm / R1037
22cm / R1038
22cm / R1039
22cm / R1040
22cm / R1041
22cm / R1042
23cm / R1001
23cm / R1002
23cm / R1003
23cm / R1004
23cm / R1005
23cm / R1006
23cm / R1007
23cm / R1008
23cm / R1009
23cm / R1010
23cm / R1011
23cm / R1012
23cm / R1013
23cm / R1014
23cm / R1015
23cm / R1016
23cm / R1017
23cm / R1018
23cm / R1019
23cm / R1020
23cm / R1021
23cm / R1022
23cm / R1023
23cm / R1024
23cm / R1025
23cm / R1026
23cm / R1027
23cm / R1028
23cm / R1029
23cm / R1030
23cm / R1031
23cm / R1032
23cm / R1033
23cm / R1034
23cm / R1035
23cm / R1036
23cm / R1037
23cm / R1038
23cm / R1039
23cm / R1040
23cm / R1041
23cm / R1042
24cm / R1001
24cm / R1002
24cm / R1003
24cm / R1004
24cm / R1005
24cm / R1006
24cm / R1007
24cm / R1008
24cm / R1009
24cm / R1010
24cm / R1011
24cm / R1012
24cm / R1013
24cm / R1014
24cm / R1015
24cm / R1016
24cm / R1017
24cm / R1018
24cm / R1019
24cm / R1020
24cm / R1021
24cm / R1022
24cm / R1023
24cm / R1024
24cm / R1025
24cm / R1026
24cm / R1027
24cm / R1028
24cm / R1029
24cm / R1030
24cm / R1031
24cm / R1032
24cm / R1033
24cm / R1034
24cm / R1035
24cm / R1036
24cm / R1037
24cm / R1038
24cm / R1039
24cm / R1040
24cm / R1041
24cm / R1042
25cm / R1001
25cm / R1002
25cm / R1003
25cm / R1004
25cm / R1005
25cm / R1006
25cm / R1007
25cm / R1008
25cm / R1009
25cm / R1010
25cm / R1011
25cm / R1012
25cm / R1013
25cm / R1014
25cm / R1015
25cm / R1016
25cm / R1017
25cm / R1018
25cm / R1019
25cm / R1020
25cm / R1021
25cm / R1022
25cm / R1023
25cm / R1024
25cm / R1025
25cm / R1026
25cm / R1027
25cm / R1028
25cm / R1029
25cm / R1030
25cm / R1031
25cm / R1032
25cm / R1033
25cm / R1034
25cm / R1035
25cm / R1036
25cm / R1037
25cm / R1038
25cm / R1039
25cm / R1040
25cm / R1041
25cm / R1042
Taille de cheville
20cm
21cm
22cm
23cm
24cm
25cm
Couleur 01
R1001
R1002
R1003
R1004
R1005
R1006
R1007
R1008
R1009
R1010
R1011
R1012
R1013
R1014
R1015
R1016
R1017
R1018
R1019
R1020
R1021
R1022
R1023
R1024
R1025
R1026
R1027
R1028
R1029
R1030
R1031
R1032
R1033
R1034
R1035
R1036
R1037
R1038
R1039
R1040
R1041
R1042
Pendentifs
Mini fleur tropicale rose BD018 (+ 0,50 €)
Mini fleur tropicale violette BD018 (+ 0,50 €)
Fleur tropicale blanche BD012 (+ 1,00 €)
Merci ! Vous recevrez un e-mail lorsque ce produit sera de nouveau en stock.
Bijoux de cheville avec son pendentif Fleur. Perles de Taille 1
Vous avez simplement à sélectionner la couleur de votre choix *
Choisissez votre pendentif préféré
Indiquez votre taille de cheville **
Et Kréa by Tracy réalisera pour vous, votre bijoux de cheville sur mesure. * Si vous souhaitez une autre couleur, il vous suffit de le notifier avec un message à l'attention du vendeur , avec la référence que vous désirez ajouter à votre bijoux de cheville. ** Si votre taille n'apparaît pas dans les tailles proposées, hésitez pas à envoyer un message à l'attention du vendeur avec la taille que vous souhaitez.